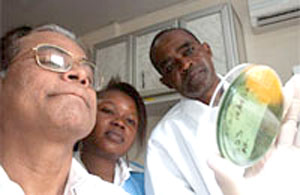

Ngày 29/4/2015. GENEVA - Báo cáo của Tổ chức Y tế thế giới (WHO) cho biết thiếu các hệ thống chống lại sự đề kháng với thuốc kháng sinh (WHO report finds systems to combat antibiotic resistance lacking). Một phần tư các nước đáp ứng với một cuộc khảo sát của WHO cho biết là có kế hoạch quốc gia nhằm bảo quản các loại thuốc kháng khuẩn như thuốc kháng sinh nhưng nhiều quốc gia khác cũng cần phải đẩy mạnh.
|
| Ảnh: Felicity Thompson/WHO |
Một báo cáo mới:"Phân tích tình hình các quốc gia trên toàn thế giới: Đáp ứng tới sự đề kháng của các thuốc kháng khuẩn" (Worldwide country situation analysis: Response to antimicrobial resistance), chỉ ranhững phát hiện của cuộc khảo sát và cho thấy rằng trong khi nhiều hoạt động đang được tiến hành và nhiều chính phủ đang cam kết giải quyết vấn đề này thì vẫn có những khoảng trống lớn các hành động cần thiết trên tất cả 6 khu vực của WHO để ngăn chặn việc lạm dụng kháng sinh và làm giảm sự lây lan việc đề kháng với kháng sinh. "Đây là thách thức lớn nhất đối với các bệnh truyền nhiễm hiện nay", Tiến sĩ Keiji Fukuda-Trợ lý Tổng giám đốc WHO về An ninh Y tế cho biết (General for Health Security): "Tất cả các loại vi khuẩn, trong đó có nhiều loại virus và ký sinh trùng đang trở nên kháng thuốc. Mối quan tâm đặc biệt cấp bách là sự phát triển của vi khuẩn ít bị tác động bởi các thuốc kháng sinh có sẵn đang xảy ra ở tất cả các nơi trên thế giới, vì vậy tất cả các quốc gia phải thực hiện bổn phận của mình để giải quyết mối đe dọa toàn cầu này. Trong khi có rất nhiều việc phải được khuyến khích và còn nhiều việc cần phải được thực hiện để chống lại một trong những mối đe dọa sức khỏe toàn cầu nghiêm trọng nhất trong thời đại chúng ta".
Được phát hành một năm sau báo cáo đầu tiên của WHO về mức độ kháng thuốc trên toàn cầu, trong đó cảnh báo về một "kỷ nguyên hậu kháng sinh" (post-antibiotic era), mà cuộc khảo sát này được hoàn thành ở 133 quốc gia vào năm 2013 và 2014, là báo cáo đầu tiên nắm bắt đánh giá của chính các chính phủ về đáp ứng của họ tới sự đề kháng với thuốc kháng sinh được sử dụng để chữa các bệnh như nhiễm trùng máu, viêm phổi, bệnh lao (TB), sốt rét và HIV. Báo cáo tóm tắt hoạt động hiện hành và các cấu trúc nhằm giải quyết vấn đề này, và cho thấy có những lĩnh vực quan trọng cần cải thiện."Trong khi có rất nhiều việc phải được khuyến khích và còn nhiều việc cần phải được thực hiện để chống lại một trong những mối đe dọa sức khỏe toàn cầu nghiêm trọng nhất trong thời đại chúng ta", Ttiến sĩ Fukuda nói: "Các nhà khoa học, các nhà lâm sàng và các cơ quan khác như WHO đã gióng lên hồi chuông cảnh báo về tác động đầy thảm họa khi bỏ qua sự đề kháng của kháng sinh. Hôm nay, chúng tôi hoan nghênh những gì đã đạt được cho đến nay, nhưng nhiều việc hơn nữa cần phải được thực hiện để tránh làm mất khả năng thực hành y khoa và điều trị các bệnh phổ biến và nghiêm trọng".
Các phát hiện chủ yếu của báo cáo bao gồm (Key findings of the report include)
Rất ít quốc gia (34 trong tổng số 133quốc gia tham gia khảo sát) có một kế hoạch quốc gia toàn diện để chống lại khả năng kháng thuốc kháng sinh và các loại thuốc kháng khuần khác. Giám sát là chìa khóa để kiểm soát sự đề kháng với kháng sinh, nhưng việc này là không thường xuyên. Ở nhiều quốc gia, năng lực của phòng xét nghiệm là nghèo nàn, cơ sở hạ tầng và xử lý dữ liệu đang ngăn chặn hiệu quả giám sát, và việc giám sát có thể phát hiện mô hình của sự đề kháng và xác định các xu hướng và sự bùng phát. Doanh số bán ra của kháng sinh và các loại thuốc kháng khuẩn khác mà không cần kê đơn bác sĩ vẫn còn phổ biến rộng rãi, và nhiều quốc gia thiếu các hướng dẫn điều trị chuẩn làm tăng khả năng việc lạm dụng các thuốc kháng khuẩn bởi các chuyên gia y tế và công cộng. Ý thức của công chúng về vấn đề này còn thấp ở tất cả các vùng, và nhiều người vẫn tin rằng kháng sinh có hiệu quả chống lại các nhiễm trùng dovirus. Thiếu các chương trình phòng ngừa và kiểm soát các nhiễm trùng mắc phải ở bệnh viện vẫn còn một vấn đề lớn.
WHO, các nước và các đối tác đã phát triển một dự thảo Kế hoạch hành động toàn cầu để chống lại sự đề kháng với các thuốc kháng khuẩn bao gồm cả sự đề kháng với kháng sinh, mà đã được đệ trình lên kỳ họp lần thứ 68 của Đại Hội đồng Y tế thế giới sẽ diễn ra vào tháng 5 năm 2015. Các chính phủ sẽ được yêu cầu phê duyệt kế hoạch và, khi làm như vậy, tuyên bố cam kết của họ để giải quyết một vấn đề đang đe dọa sức khỏe toàn cầu như chúng ta biết. Một bước quan trọng trong việc thực hiện Kế hoạch hành động toàn cầu sẽ là sự phát triển các kế hoạch quốc gia toàn diện ở các nước nơi mà họ đang thiếu và tiếp tục phát triển và tăng cường các kế hoạch hiện có.
Các điểm nhấn trong báo cáo ở các khu vực của WHO (Highlights of report by WHO region)
Khu vực châu Phi của WHO (WHO African Region)
8 trong số 47 nước thành viên trong khu vực tham gia cuộc khảo sát), Các dữ liệu trong khu vực này không đầy đủ do thiếu thông tin, tuy nhiên kết quả cho thấy rằng sự đề kháng với các thuốc kháng khuẩn là một vấn đề ngày càng tăng. Tất cả 8 quốc gia trong khu vực đáp ứng rằng sự đề kháng với các thuốc dùng để điều trị bệnh sốt rét và bệnh lao là thách thức lớn nhất của họ. Thuốc kém chất lượng (poor-quality medicines) là một vấn đề chung, tiếp tục đóng góp cho sự thách thức.
Khu vực châu Mỹ của WHO (WHO Region of the Americas)
26 trong số 35 nước thành viên trong khu vực tham gia cuộc khảo sát, chỉ có 3 nước trong khu vực báo cáo có một kế hoạch quốc gia, đa ngành để giải quyết sự đề kháng với các thuốc kháng khuẩn, rất ít quốc gia cho biết có một bản báo cáo về giám sát kháng thuốc ở người. Thuốc kháng sinh và các loại thuốc kháng khuẩn khác là có sẵn trên các quầy dược ở18 quốc gia, chỉ 10 quốc gia có các hướng dẫn điều trị chuẩn.
Khu vực Đông Địa Trung Hải của WHO (WHO Eastern Mediterranean Region)
13 trong số 21 nước thành viên trong khu vực tham gia cuộc khảo sát, không có ai trong số các quốc gia này báo cáo có một kế hoạch hành động quốc gia giải quyết về sự đề kháng với các thuốc kháng khuẩn. Nhiều lỗ hổng được phát hiện trong việc giải quyết vấn đề này. Đây không phải là điều đáng ngạc nhiên vì có các trường hợp khẩn cấp khác trong khu vực, bao gồm thiên tai và xung đột, có sự hiểu biết và nhận thức kém trong tất cả các lĩnh vực công cộng. 3 nước đã tiến hành một chiến dịch thông tin công cộng trong 2 năm trước đó. Thuốc kháng sinh và các loại thuốc kháng khuẩn khác là có sẵn mà không cần toa bác sĩ ở 9 quốc gia.
Khu vực châu Âu của WHO (WHO European Region)
49 trong số 53 nước thành viên trong khu vực tham gia cuộc khảo sát, 40% của các nước thông báo có các chiến lược và kế hoạch toàn diện để giải quyết sự đề kháng với các thuốc kháng khuẩn. Tất cả các nước EU tiến hành giám sát kháng thuốc ở vi khuẩn thông qua Mạng lưới giám sát sự đề kháng với các thuốc kháng khuẩn châu Âu (European Antimicrobial Resistance Surveillance Network_EARS-Net) và được thúc đẩy bởi Trung tâm Phòng ngừa và Kiểm soát dịch bệnh châu Âu Khoảng một nửa các quốc gia đều có một chương trìnhphòng ngừa và kiểm soát bệnh truyền nhiễm quốc gia và các chiến dịch thông tin công cộng rất phổ biến, tuy nhiên khoảng một nửa người dân tin rằng kháng sinh có hiệu quả chống lại virus.
Khu vực Đông Nam Á của WHO (WHO South-East Asia Region)
Tất cả 11 nước thành viên trong khu vực tham gia cuộc khảo sát, 5 trong số 11 quốc gia có kế hoạch quốc gia để giải quyết sự đề kháng với các thuốc kháng khuẩn Giám sát việc sử dụng kháng sinh và các loại thuốc kháng khuẩn khác bị hạn chế, và các thuốc này là có sẵn mà không cần toa ở hơn một nửa các quốc gia. 9 trong số11 quốc gia có một chương trình phòng chống và kiểm soát quốc gia và một số quốc gia tương tự có một cơ quan quản lý ở tầm quốc gia chịu trách nhiệm về việc bảo đảm chất lượng thuốc, nhưng nhiều nước báo cáo các nhân viên y tế thực hiện kém theo các hướng dẫn và tiêu chuẩn kê đơn. Nhận thức của cộng chúng trong khu vực đang gia tăng- 5 quốc gia báo cáo tiến hành các hoạt động nâng cao nhận thức trong 2 năm trước đó. Bộ trưởng Bộ Y tế của khu vực nêu cam kết của họ trong việc ngăn chặn và kiểm soát sự đề kháng với các thuốc kháng khuẩn thông qua Tuyên bố Jaipur trong năm 2011.
Khu vực Tây Thái Bình Dương của WHO (WHO Western Pacific Region)
26 trong số 27 nước thành viên trong khu vực tham gia cuộc khảo sát, 4 trong số các quốc gia báo cáo (17%) có kế hoạch hành động quốc gia. Gần 70% các nước báo cáo giám sát kháng kháng sinh của vi khuẩn; Tỷ lệ này có thể tăng theo sau việc thực hiện hệ thống giám sát về sự đề kháng với các thuốc kháng khuẩn ở Tây Thái Bình Dương trong tương lai gần. 2/3 trong số các nước báo cáo có một chương trình IPC. Có sự thực thi yếu kém về các quy định trong việc bán thuốc kháng sinh và các loại thuốc kháng khuẩn khác mà không cần toa bác sĩ và các tiêu chuẩn chất lượng.
Ghi chú của Ban biên tập (Notes to editors)
133 nước đã tham gia vào cuộc khảo sát:
Khu vực châu Phi của WHO (WHO African Region)
Burkina Faso, Central African Republic, Gambia, Ghana, South Sudan, United Republic of Tanzania, Uganda, Zambia.
Khu vực châu Mỹ của WHO (WHO Region of the Americas)
Antigua and Barbuda, Argentina, Barbados, Belize, Bolivia (Plurinational State of), Brazil, Canada, Chile, Colombia, Costa Rica, Cuba, Dominica, Dominican Republic, Ecuador, El Salvador, Guatemala, Guyana, Honduras, Jamaica, Mexico, Nicaragua, Paraguay, Peru, Saint Kitts and Nevis, Suriname, Uruguay.
Khu vực Đông Địa Trung Hải của WHO (WHO Eastern Mediterranean Region)
Afghanistan, Bahrain, Egypt, Iran (Islamic Republic of), Jordan, Lebanon, Morocco, Oman, Pakistan, Saudi Arabia, Sudan, Syrian Arab Republic, United Arab Emirates.
Khu vực châu Âu của WHO (WHO European Region)
Albania, Armenia, Austria, Azerbaijan, Belarus, Belgium, Bosnia and Herzegovina, Bulgaria, Croatia, Cyprus, Czech Republic, Denmark, Estonia, France, Georgia, Germany, Greece, Hungary, Iceland, Ireland, Israel, Italy, Kazakhstan, Kyrgyzstan, Latvia, Lithuania, Luxembourg, Malta, Montenegro, Netherlands, Norway, Poland, Portugal, Republic of Moldova, Romania, Russian Federation, Serbia, Slovakia, Slovenia, Spain, Sweden, Switzerland, Tajikistan, The former Yugoslav Republic of Macedonia, Turkey, Turkmenistan, Ukraine, United Kingdom, Uzbekistan.
Khu vực Đông Nam Á của WHO (WHO South-East Asia Region)
Bangladesh, Bhutan, Democratic People’s Republic of Korea, India, Indonesia, Maldives, Myanmar, Nepal, Sri Lanka, Thailand, Timor-Leste.
Khu vực Tây Thái Bình Dương của WHO (WHO Western Pacific Region)
Australia, Brunei Darussalam, Cambodia, China, Cook Islands, Fiji, Japan, Kiribati, Lao People's Democratic Republic, Malaysia, Marshall Islands, Micronesia (Federated States of), Mongolia, New Zealand, Niue, Palau, Papua New Guinea, Philippines, Republic of Korea, Samoa, Singapore, Solomon Islands, Tonga, Tuvalu, Vanuatu, Viet Nam.